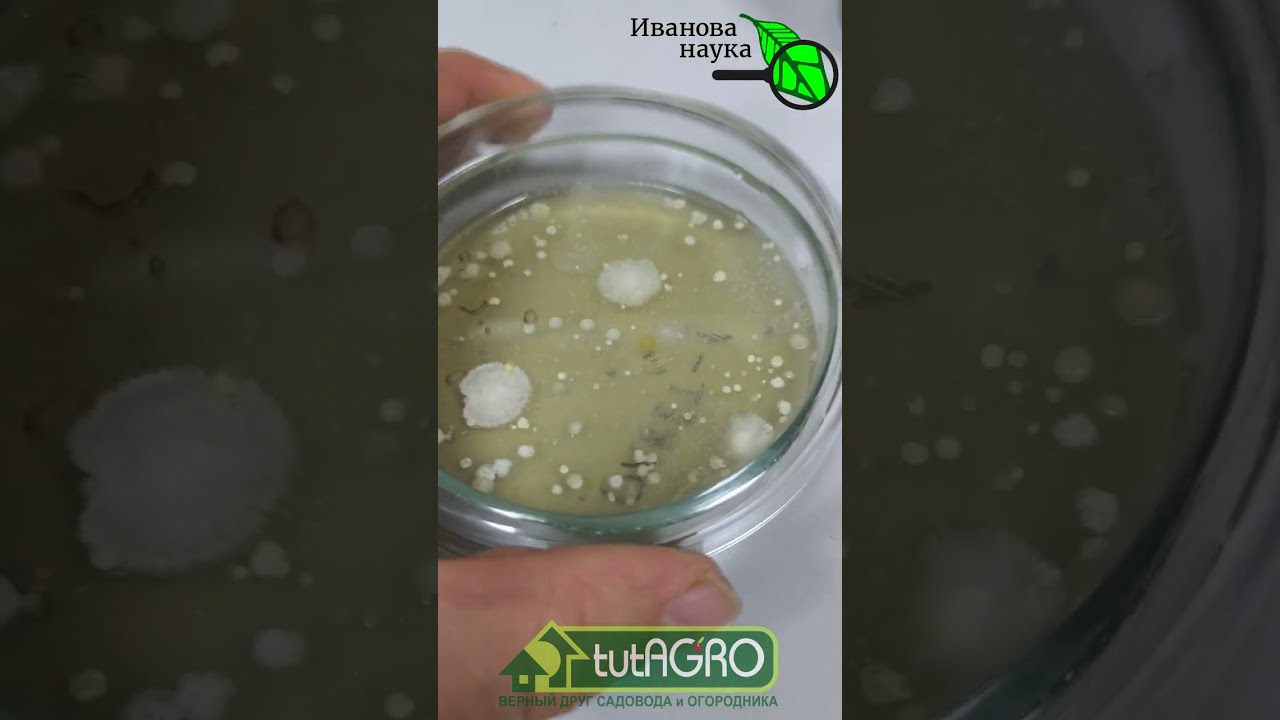
ГОРСТЬ ЗЕМЛИ - ЛУЧШЕ ДОРОГОГО ПРЕПАРАТА! Вместо покупных препаратов - обычна?

MARKETలో Bubble ఎప్పుడైనా burst అవ్వచ్చు| Groww results ఎలా ఉన్నాయి| Sudeep Pharma
Zerodha Account Link 👉 https://zerodha.com/open-account?c=ZMPVNWAngel Broking 👉 https://angel-one.onelink.me/Wjgr/8vxyj8iq
UPSTOX 👉 https://tinyurl.com/y8sbw9w8
FLYERS 👉 https://bit.ly/3JZwgyc
Buy Best Term/Health Insurance With Spam-free Advice - https://ditto.sh/1bzezx
TELEGRAM: https://telegram.openinapp.co/money-purse
Moneypurse Get Fit Family 👉 https://strava.app.link/4U0TAr1zzTb
Follow our WhatsApp channel 👉 https://tinyurl.com/32cra3sc
You can learn the basics of Stock markets for beginners, How to do Fundamental Analysis of a stock or any company, Expert Interviews, Financial Planning, tax planning, daily stock market news, and many more for free in our channel
Get free knowledge and learn how to be a pro in stock market investments and your personal finance.
Stay In Touch 👇
Also connect with us on👇
📷Instagram: https://www.instagram.com/moneypurseadv/
🕊Twitter: https://twitter.com/Moneypurseadv
📱Facebook: https://www.facebook.com/moneypurseadv/
Thanks for watching.
Team Money Purse
00:00 Market Update
03:27 China Good news to these stocks
04:32 Sudeep pharma IPO
13:00 Friday Question
13:36 Reliance Industries
14:47 Godrej Properties
15:43 Kotak mahindra bank
16:50 Hindaloco
17:29 Indigo
18:13 Indusland Bank
18:45 Ather Energy
19:11 JyotiCnc Automation Ltd
19:42 KNR Constructions Ltd
20:08 Grow Results
Disclaimer: We are not SEBI registered. Before taking any positions, contact your financial advisor. we are not responsible for any Profits or losses; whatever we are providing here is purely educational and informational point of view Receive SMS online on sms24.me
TubeReader video aggregator is a website that collects and organizes online videos from the YouTube source. Video aggregation is done for different purposes, and TubeReader take different approaches to achieve their purpose.
Our try to collect videos of high quality or interest for visitors to view; the collection may be made by editors or may be based on community votes.
Another method is to base the collection on those videos most viewed, either at the aggregator site or at various popular video hosting sites.
TubeReader site exists to allow users to collect their own sets of videos, for personal use as well as for browsing and viewing by others; TubeReader can develop online communities around video sharing.
Our site allow users to create a personalized video playlist, for personal use as well as for browsing and viewing by others.
@YouTubeReaderBot allows you to subscribe to Youtube channels.
By using @YouTubeReaderBot Bot you agree with YouTube Terms of Service.
Use the @YouTubeReaderBot telegram bot to be the first to be notified when new videos are released on your favorite channels.
Look for new videos or channels and share them with your friends.
You can start using our bot from this video, subscribe now to MARKETలో Bubble ఎప్పుడైనా burst అవ్వచ్చు| Groww results ఎలా ఉన్నాయి| Sudeep Pharma
What is YouTube?
YouTube is a free video sharing website that makes it easy to watch online videos. You can even create and upload your own videos to share with others. Originally created in 2005, YouTube is now one of the most popular sites on the Web, with visitors watching around 6 billion hours of video every month.